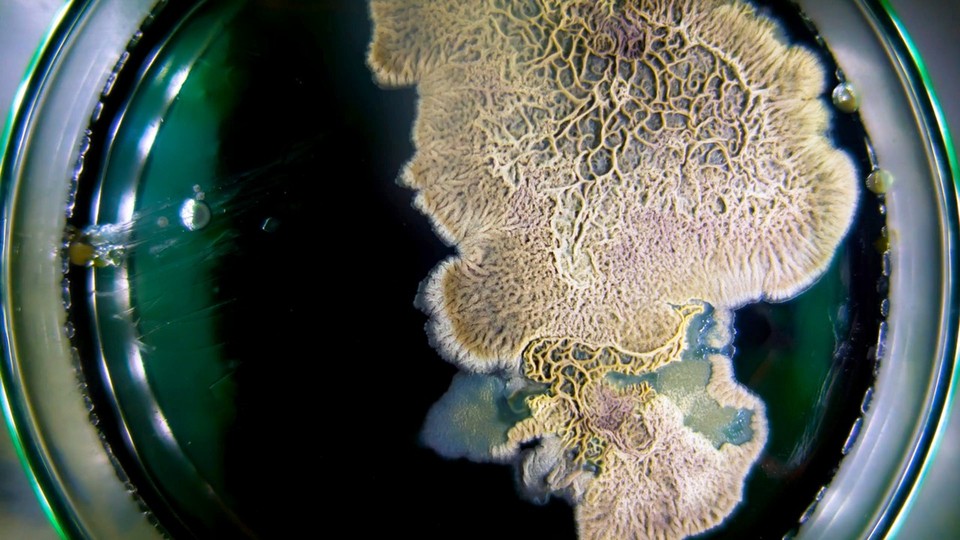

Antibiotika
Finns även som Teckenspråkstolkat · Utan tolkning
Om programmet
Antibiotikan revolutionerade världen, men numera har antibiotikaresistensen blivit ett stort globalt problem. Utan antibiotika blir kroppen enormt sårbar. Forskning pågår kring bakteriofager och enzymet lysin kan vara en lösning.
- Ämnesord:
- Antibiotika, Antibiotikaresistens, Encymer, Kemi, Medicin, Medicinsk forskning, Naturvetenskap, Organisk kemi
- Produktionsår
- 2019
- Tillgänglig till
- 30 juni 2027
- Talat språk
- Engelska, Svenska
- Undertexter
- Svenska
- Medverkande
- Johan Seijsing, Malin Grape, Richard Henderson
Dela programmet
Pedagogiskt syfte
Syftet med serien är att belysa aktuella forskningsområden inom fysik, kemi och biologi.
- Utbildningsnivå:
- Grundskola 7-9
- Ämne:
- Biologi, Kropp och hälsa
Vi har för närvarande inget arbetsmaterial för detta program.
Läs mer om hur vi arbetar med pedagogik och arbetsmaterial